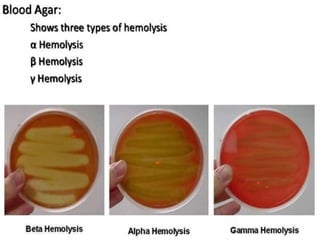

The document provides an extensive overview of streptococci, including their classification, characteristics, pathogenic mechanisms, clinical manifestations, and associated diseases. Key groups such as Streptococcus pyogenes and Streptococcus agalactiae are discussed in detail, highlighting their roles in infections like pharyngitis, scarlet fever, and neonatal meningitis. Additionally, it covers diagnostic methods, treatment options, and the prevention of associated diseases.